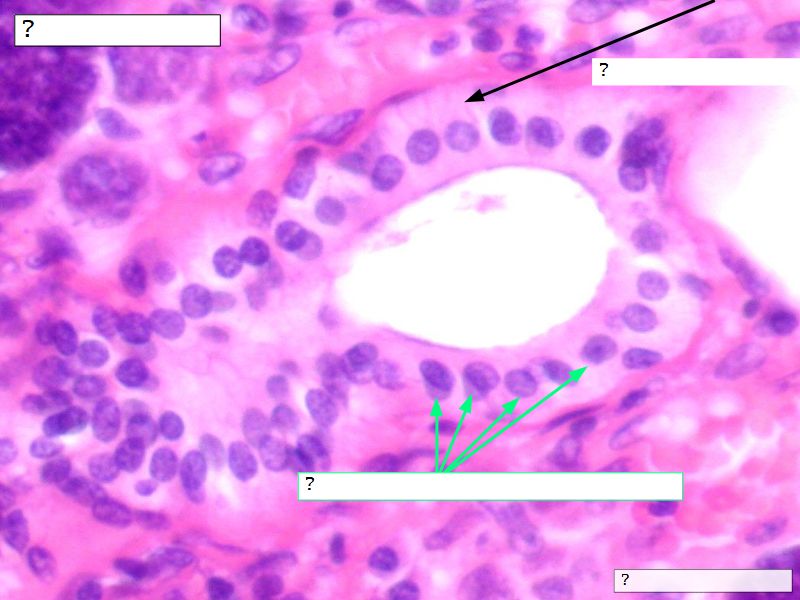

Revision
Fill in all the missing labels, and assess as you move through the slides. Answers on the down slide. It is important to do this using pen and paper, and not just glance through the images.
- esc key shows all the slides
- arrows left right advance the slide
- mobile device swipe left right
- slides can go left-right and up-down
- ? gives instant help
- menu bottom left
How to get the most from the revision slides
- Have a pen & paper ready
- Answer every question
- Mark your answer after answering
- Elaborate on each answer
- Add relevant clinical content
- If you have trouble, ask
Philosophy 1
What is the least amount of work I can do so I can get out of here.
Philosophy 2
Today and Now I will do something for my future self.